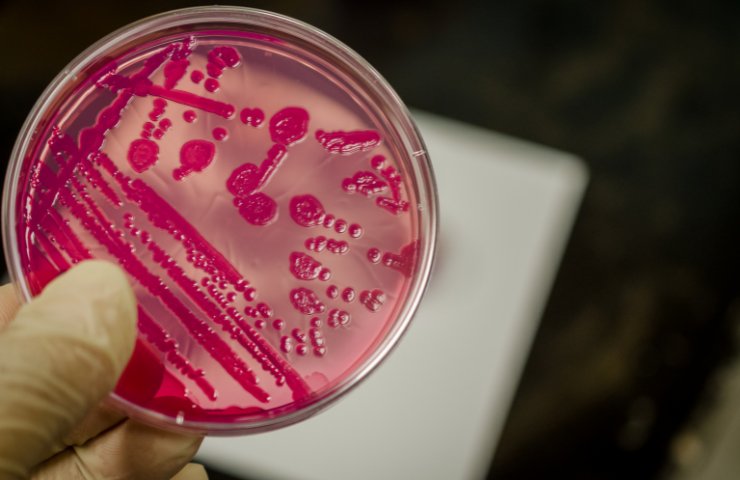
Batteri della Salmonella

Scatta l’allarme Salmonella per una epidemia deflagrata su una precisa porzione di territorio nel nostro Paese. Già tanti i presunti casi di contaminazione, cosa stanno facendo le autorità preposte.
Epidemia di Salmonella, una provincia è diventata teatro di una preoccupante serie di casi sospetti di salmonellosi. Più di cinquanta persone nella zona hanno manifestato sintomi compatibili con un’intossicazione alimentare da salmonella, e tra di loro tre hanno dovuto essere ricoverate in ospedale. Il dato è stato reso noto dal Dipartimento di Sanità Pubblica dell’AUSL Reggio Emilia, che ha avviato una indagine epidemiologica.

E lo ha fatto assieme all’Istituto Zooprofilattico Sperimentale della Lombardia e dell’Emilia‑Romagna (IZSLER) per stabilire se si tratti di un unico focolaio o di una molteplicità di fonti contaminanti. È difatti la provincia di Reggio Emilia ad essere coinvolta in questa epidemia di Salmonella. E l’indagine epidemiologica ha evidenziato un dato significativo.
Allarme Salmonella a Reggio Emilia, la situazione
La maggior parte delle persone coinvolte aveva consumato, nei giorni precedenti l’insorgenza dei sintomi gastrointestinali, pasti in pubblici esercizi – ristoranti o locali della provincia di Reggio Emilia – e pertanto le autorità sanitarie hanno avviato ispezioni negli esercizi e nei relativi fornitori alimentari. Uno dei casi documentati ha riguardato una preparazione vegetale in ristorante nella quale è stato isolato il batterio.
Curiosamente, quella portata appariva priva dei pomodorini siciliani spesso associati a precedenti focolai. Al momento non è stato confermato alcun legame diretto con i pomodorini siciliani, sebbene non sia possibile escluderlo: alcuni precedenti focolai europei legati al sierotipo Strathcona erano riconducibili proprio a pomodorini contaminati da acqua di irrigazione inquinata.
Poiché in Italia in particolare frutta e verdura vengono spesso consumati crudi, questo rappresenta un fattore di rischio accertato. Gli alimenti freschi non cotti richiedono maggiori precauzioni igieniche rispetto alle carni o uova che sono abitualmente consumate cotte. Le autorità sanitarie locali e regionali hanno emesso una serie di raccomandazioni per la popolazione.
Come evitare rischi
Ci vogliono lavaggio accurato di frutta e verdura, evitare carni e uova poco cotte, buona igiene delle mani e degli utensili. Separazione tra alimenti crudi e cotti e conservazione corretta degli alimenti. Inoltre è stato sottolineato che, sebbene la salmonellosi non tifoidea sia in genere lieve e autolimitante per la maggior parte degli adulti sani, può richiedere il ricovero in soggetti fragili, bambini o anziani.

In sintesi, l’ondata di casi sospetti di salmonella nella provincia di Reggio Emilia rappresenta una preoccupazione per la salute pubblica. Più di cinquanta segnalazioni, tre ricoveri, numerosi ceppi diversi individuati e indagini in corso su locali e fornitori.
Sebbene non sia ancora confermata una fonte unica, è già evidente la necessità di rafforzare le pratiche di igiene alimentare e controllo. Soprattutto in contesti dove il consumo di alimenti crudi o poco trattati è frequente. La collaborazione tra AUSL locale, IZSLER e autorità di controllo sarà determinante per identificare le cause, interrompere la catena di contaminazione e prevenire ulteriori casi.
I risultati preliminari delle analisi
Le prime analisi sono già in corso: delle oltre cinquanta segnalazioni, circa trenta sono state confermate come reali infezioni da salmonella, mentre i ceppi batterici sono stati inviati all’IZSLER per la tipizzazione. Secondo il responsabile del Centro regionale per i patogeni enterici sono già stati analizzati dieci ceppi: sono emersi quattro sierotipi diversi tra i campioni esaminati.
Questo risultato suggerisce che probabilmente non ci sia un solo focolaio unico. Ma multiple fonti o vie di contagio che hanno provocato l’attuale ondata di casi. Tra i sierotipi individuati figura anche Salmonella Strathcona. Che è classificata come rara, ma già coinvolta in un focolaio europeo che ha colpito 19 paesi e oltre 400 persone, delle quali 123 in Italia.
La presenza di questo sierotipo in alcuni campioni della provincia suggerisce che l’episodio locale possa essere collegato a una contaminazione più ampia o integrata nel contesto europeo.






